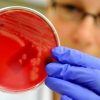

Seis lugares que estão vencendo a guerra contra os carros
Evolução das bactérias “invencíveis” ameaça futuro da humanidade

China se irrita com manobra naval dos EUA e aciona dois destróieres

Aeromoças sofrem abusos em 'ritual de iniciação' e incidente gera revolta

Sua mãe ou a namorada, quem você salvaria de um prédio em chamas?

Explosão na China que matou mais de 50 pôde ser vista do espaço

Grande explosão deixa centenas de feridos na China

Mãe salva filho antes de morrer em escada rolante
